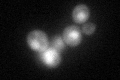
YDR177W
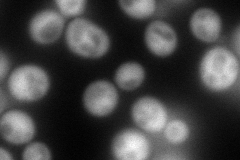
YDR177W
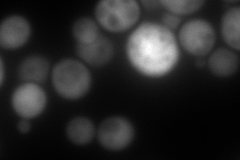
YDR177W
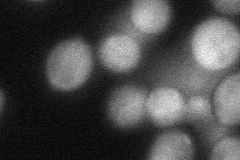
YDR177W
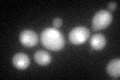
YDR177W
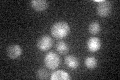
YDR177W

View description
Ubiquitin-conjugating enzyme that mediates selective degradation of short-lived and abnormal proteins; plays a role in vesicle biogenesis and ER-associated protein degradation (ERAD); component of the cellular stress response
Localization:
Intensity:
Fold change:
Significance:
-
C’ GFP library in SD
nucleus:cytosol61.15 -
N' NOP1pr-GFP in SD
cytosol185.482 -
N' TEF2pr-mCherry in SD
cytosol302.826 -
N' NATIVEpr-GFP in SD

cytosol85.3367 -
N' TEF2pr-VC and Cyto-VN in SD
cytosol48.8799 -
C’ GFP library in SD+DTT
nucleus.cytosol50.840.83No -
C’ GFP library in SD+H2O2

nucleus.cytosol35.270.57Yes -
C’ GFP library in Starvation Media
nucleus,cytosol29.940.48Yes -
C’ GFP library on the background of Pup2-DaMP

nucleus:cytosol -
C’ GFP library on the background of CCT mutant

nucleus:cytosol53.30280.871517No
